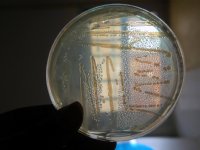

Artikelen: antibiotica
Overzichtspagina artikelen: 'antibiotica' op Nieuweoogst.nl. Voor overige onderwerpen kunt u onze zoekfunctie (rechtsboven) gebruiken of bekijk het nieuwsarchief.
-
Antibioticagebruik Duitse varkenshouder daalt minder hard
18-02-2021 - Het antibioticagebruik op Duitse varkensbedrijven daalde in 2020 verder, maar de daling vlakt wel af. Dat blijkt uit de voorlopige cijfers van het QS-systeem. Ten opzichte van 2019 daalde...
-
Aanpak antibiotica varkenshouderij per 1 januari 2021 in IKB's
25-11-2020 - Een plan van aanpak om het antibioticagebruik op rode bedrijven te verlagen, wordt per 1 januari 2021 opgenomen in de IKB's. Groene bedrijven worden op deze manier 'met rust gelaten' en...
-
IKB ei vraagt aandacht voor colistinegebruik
30-10-2020 - Kwaliteitszorgsysteem IKB ei vraagt in een nieuwsbrief aandacht voor het gebruikt van de werkzame stof colistine in de legsector. Het antibioticagebruik is volgens IKB ei laag, maar 68...
-
Benchmark antibioticagebruik dierenartsen in nieuw jasje
07-10-2020 - Er komt een nieuwe benchmark om het antibioticagebruik door dierenartsen te monitoren. Daarbij ligt de focus op het gemiddeld aantal dagen dat een dier per jaar wordt behandeld met...
-
POV: 'Waardering voor inzet varkenshouders op zijn plaats'
23-07-2020 - Het antibioticagebruik in de varkenshouderij blijft ieder jaar afnemen. In elke diercategorie is in 2019 opnieuw vooruitgang geboekt. 'Ik denk dat een breed publiek geen weet heeft van de...
-
Coaching helpt een rood bedrijf in het groen
22-07-2020 - De varkenshouderij heeft de afgelopen tien jaar het antibioticagebruik met grote stappen teruggebracht. De focus komt nu te liggen op de 'rode bedrijven' met een structureel te hoge...
-
Antibioticagebruik in de dierhouderij neemt verder af
10-06-2020 - Het gebruik van antibiotica in de veehouderij is in 2019 ten opzichte van 2018 opnieuw afgenomen. Dat laat de Autoriteit Diergeneesmiddelen (SDa) weten.
-
ESBL's kunnen overgaan van varkens naar mensen
22-05-2020 - Wanneer varkens ESBL's meedragen, kunnen deze worden overgedragen op mensen door direct contact. Het promotieonderzoek van Wietske Dohmen aan de Universiteit Utrecht toont dit aan.
-
Correct ontsmetten voorkomt resistentie
21-03-2020 - Ontsmettingsmiddelen die correct worden toegepast, veroorzaken geen antimicrobiële resistentie. Dat concludeert Helder Maertens van het Instituut voor Landbouw en Visserijonderzoek (ILVO)...
-
Disarm: internationale aanpak diergezondheid
04-11-2019 - Kennisdelen om dieren gezond te houden en het antibioticagebruik te reduceren. Veehouders, dierenartsen, adviseurs en onderzoekers in heel Europa bundelen hun krachten en delen kennis in...
-
NVWA pakt handelaar die illegaal antibiotica inzet
25-09-2019 - Bij een veehandelaar in Noord-Nederland is een hoeveelheid antibiotica in beslag genomen. Daarnaast confisqueerden de rechercheurs van de Inlichtingen- en Opsporingsdienst en buitengewoon...
-
Mens belangrijkste bron antibioticaresistentie
03-09-2019 - De mens is de belangrijkste bron van ESBL-antibioticaresistentie. Dat blijkt uit onderzoek van het ESBL-Attributieanalyse (ESBLAT-)consortium.
-
Minder antibioticagebruik kalkoenen en kalveren
12-06-2019 - Het antibioticagebruik in de kalkoen- en kalverhouderij daalde vorig jaar fors ten opzichte van 2017. Dat blijkt uit de jaarrapportage van de Autoriteit Diergeneesmiddelen (SDa).
-
Afmaken antibioticakuur slachtkuiken niet nodig
22-05-2019 - Antibioticumkuren bij slachtkuikens hoeven niet volledig te worden afgemaakt. Dat adviseert Bureau Risicobeoordeling & onderzoek (BuRO) de Nederlandse Voedsel- en Warenautoriteit...
-
Gebruik van pre- en probiotica bij vee neemt toe
16-05-2019 - Het gebruik van antibiotica wordt verder afgebouwd. Tegelijkertijd neemt het gebruik van pro- en prebiotica in de veehouderij toe. Een logische ontwikkeling, zegt dierenarts Johanna...
-
Varkenshouder Joost gaat voor 25 procent antibioticareductie
12-04-2019 - Varkenshouder Joost van der Pas uit Heeswijk-Dinther streeft naar 25 procent antibioticareductie. Hij is een van de varkenshouders die, om dat te realiseren, mee doet aan project...
-
Kalversector zet rem op antibiotica
14-03-2019 - Het antibioticagebruik in de vleeskalversector lag in 2018 gelijk aan het jaar ervoor. Met extra inspanningen wil de sector voor 2022 een verdere reductie van 15 procent antibiotica halen.
-
Varkenshouder Hans Gerrits wil bij besten horen
20-02-2019 - Vleesvarkenshouder Hans Gerrits hecht aan werken volgens vaste afspraken. Ook als het gaat om diergezondheid is dit voor hem essentieel. De ondernemer benut de deskundigheid van dierenarts...
-
Zeugenhouders gezocht voor onderzoek antibiotica
05-02-2019 - De Gezondheidsdienst voor Dieren (GD) en Wageningen University & Research zoeken voor een onderzoek naar 'kritische succesfactoren' in het antibioticumgebruik op varkensbedrijven nog...
-
Geitensector registreert medicijngebruik centraal
04-01-2019 - De melkgeitenhouderij gaat, op vrijwillige basis, het medicijngebruik bij geiten centraal registreren. Met de deelname kunnen ondernemers punten verdienen in het kader van de Duurzame...
-
In 2018 verdere antibioticareductie in HyCare-stal
27-12-2018 - In 2018 is het antibioticagebruik in de HyCare-stal van MS Schippers in Bladel verder teruggebracht. Bij de biggen ligt het gebruik in 2018 met 1,71 ddd per big 92 procent onder het...
-
'Gezondheid varkens moet niet uit een potje komen'
30-10-2018 - Voormalige veelgebruikers van antibiotica zijn veelvaccineerders geworden. Dat is geen goede ontwikkeling, volgens varkensarts Gerard van Eijden van Dierenartsen Animalcare. Hij pleit voor...
-
Europees verbod op preventieve inzet antibiotica
29-10-2018 - Veehouders en fokkers in de Europese Unie (EU) mogen vanaf 2022 antibiotica niet langer preventief inzetten. Alleen de dierenarts mag het middel nog voorschrijven.
-
Antibioticagebruik omlaag met hulp coach
09-10-2018 - Soms lukt het je als mens of als ondernemer niet om een bepaald doel te halen. In zo'n geval kan een coach uitkomst bieden. Die formule wordt nu ook ingezet om bedrijven die worstelen met...
-
Een veehouder is een clubcoach
05-10-2018 - Samen met mijn broer liep ik onlangs de goededoelenmarathon van Westerbork. De route is bijzonder, omdat die dwars door een stal met koeien loopt. Tijdens de marathon moest ik denken aan...
-
Koppeling tussen gebruik antibiotica en niveau resistentie
25-07-2018 - Het niveau van antibioticumresistentie in de darmen van varkens en vleeskuikens is gerelateerd aan het antibioticumgebruik. Dat stelt een internationaal team van wetenschappers in een...
-
Verdere daling antibioticagebruik veehouderij
14-06-2018 - Het antibioticumgebruik bij landbouwhuisdieren nam ook in 2017 verder af. Dat blijkt uit het jaaroverzicht antibioticagebruik in de veehouderij in 2017 van de Autoriteit Diergeneesmiddelen...
-
Vlees eten leidt niet tot meer ESBL-bacteriën
02-05-2018 - Mensen die regelmatig vlees eten dragen niet vaker ESBL-bacteriën bij zich dan vegetariërs. Dat blijkt uit onderzoek van het RIVM. ESBL- bacteriën zijn bacteriën die stoffen maken die...
-
'Nederland aan kop bij afname antibiotica'
12-04-2018 - Rogier van Sambeek van Kanters Special Products won 24 maart de titel Ondernemer van het Jaar Peel Noord 2018. Het bedrijf is wereldwijd voorloper in duurzame alternatieven voor antibiotica...
-
Verlaging antibioticagebruik eist andere aanpak S. suis
07-04-2018 - ForFarmers, Trouw en Boehringer Ingelheim kondigden deze week een grootschalig onderzoek aan naar Streptococcus suis (S. suis), bacteriën die vooral bij gespeende biggen schade aanrichten...
-
Boer mist de kennis voor natuurlijke veehouderij
01-03-2018 - Veel veehouders zien wel wat in een natuurlijke behandeling van veeziektes in plaats van antibioticagebruik. Maar ze zoeken vooral nog naar kennis, ervaring en ondersteuning bij het...
-
Homeopathie: eerst met eigen ogen zien, dan pas geloven
15-02-2018 - Vooral melkveehouders gaan zelf of met de dierenarts aan de slag met homeopathie. Maar ook pluimvee- of varkenshouders boeken goede resultaten met alternatieve geneesmiddelen.
-
Rol veehouderij bij ESBL's klein
09-02-2018 - De overdracht van ESBL gebeurt vooral tussen mensen. De rol van de veehouderij bij de verspreiding van dit enzym, dat bacteriën resistent maakt tegen sommige vormen van antibiotica, is...
-
Kennis delen cruciaal voor antibioticareductie
26-01-2018 - Het transparanter werken door de keten heen is een van de succesfactoren om het antibioticagebruik in de kalverhouderij en de vleespluimveehouderij verder te reduceren. Ook in de...
-
Dierenarts wil verbeterplan dierenwelzijn
04-01-2018 - Kees Scheepens is een van de gezichten van Caring Vets, een groep dierenartsen die vindt dat het anders moet met de intensieve veehouderij. Als het aan Scheepens ligt, komt er voor het...
-
Intensieve sectoren krijgen eigen antibioticadoelen
04-01-2018 - De intensieve veesectoren krijgen te maken met sectorspecifieke reductiedoelen voor het gebruik van antibiotica. Stichting Diergeneesmiddelenautoriteit (SDa) komt dit voorjaar met nieuwe...
-
Antibioticagebruik melkveehouderij lager dan humaan
11-11-2017 - Het antibioticagebruik in de melkveehouderij is 50 procent lager dan bij mensen in Nederland. Dat laat rundveedierenarts Henk van Ruitenbeek namens De Oosthof Dierenartsen weten. Hij...
-
'Nog stappen zetten bij preventief antibioticagebruik'
09-11-2017 - Er wordt in Nederland al jaren geen antibiotica meer preventief ingezet, toch zijn er nog zeker stappen te maken. Dat zegt eigenaar Mark Schippers van MS Schippers in reactie op het rapport...
-
WHO wil einde aan antibiotica bij gezonde dieren
08-11-2017 - De Wereldgezondheidsorganisatie (WHO) roept veehouders over de hele wereld op te stoppen met het gebruik van antibiotica bij gezonde dieren. Het medicijn zou in de veehouderij niet meer...
-
Biggen spenen zonder zink en antibiotica
26-09-2017 - Als reactie op de veranderende wetgeving specialiseren veevoederbedrijven zich in biggenvoeding. Innovatiemanager biggenvoeders Jan Fledderus van ForFarmers richt zich niet op de vervanging...
-
Zinkoxide als diergeneesmiddel uit de markt
14-07-2017 - Alle in de EU toegelaten diergeneesmiddelen met zinkoxide moeten binnen vijf jaar van de Europese markt zijn. De handelsvergunningen van deze diergeneesmiddelen worden, met een...
-
Onderzoek antibioticareductie vlot niet
14-07-2017 - Het onderzoek van het ministerie van Economische Zaken, dat moet leiden tot verdere antibioticareductie, loopt vertraging op. De eerste fase zou deze zomer zijn afgerond, maar dat wordt dit...
-
'Antibioticadaling prestatie van wereldformaat'
31-05-2017 - Er wordt steeds minder antibiotica gebruikt in de veehouderij. 'Een prestatie van wereldformaat', stelt Jeanette van de Ven van LTO Gezonde Dieren
-
Internationale erkenning Nederlands antibioticabeleid
11-03-2017 - Nederland kan internationaal dienen als schoolvoorbeeld in het verder terugdringen van het antibioticagebruik in de veehouderij.
-
Snelle touwtest toont antibiotica aan
01-03-2017 - Het Belgische onderzoeksinstituut ILVO ontwikkelde voor de Belgische vleesverwerkende industrie een snelle touwtest. Die kan antibioticaresiduen in speeksel van varkens aantonen.
-
Zet Van Dam de humane gezondheid op het spel?
19-12-2016 - Niets baart een mens zoveel zorgen als zijn gezondheid. Dat bleek andermaal tijdens het algemeen overleg in de Tweede Kamer over dierenwelzijn. Staatssecretaris Martijn van Dam (EZ) verwees...
-
SDa vindt extra aanpak antibiotica niet nodig
14-10-2016 - De overheid hoeft niet in te grijpen om een verdere antibioticareductie te bewerkstelligen. Dat stelt voorzitter Jos Werner van de Autoriteit Diergeneesmiddelen (SDa).
-
Schippers naar VN om antibioticaresistentie
17-09-2016 - Minister Edith Schippers (Volksgezondheid) benadrukt woensdag in New York het belang van een wereldwijde samenwerking in de strijd tegen antibioticaresistentie.
-
Antibioticagebruik vleeskuikens daalt
15-09-2016 - Het gebruik van antibiotica bij vleeskuikenbedrijven is in de eerste helft van 2016 gedaald naar 9,9 dierdagdosering per jaar.
-
'Antibioticavrij varkensvlees produceren kan ook in Vietnam'
23-07-2016 - Royal De Heus zette in 2008 de eerste schreden in Azië. In Vietnam om precies te zijn. Global director Marketing en Communication, Joost Belt, deelt enkele ervaringen.
-
'Antibioticavrij varkensvlees produceren kan ook in Vietnam'
23-07-2016 - Royal De Heus zette in 2008 de eerste schreden in Azië. In Vietnam om precies te zijn. Global director Marketing en Communication, Joost Belt, deelt enkele ervaringen.
-
'Koe lost milde mastitis vaak zelf op'
15-07-2016 - Een milde mastitis wordt volgens Henk van Ruitenbeek, dierenarts bij De Oosthof Dierenartsen, regelmatig onnodig behandeld.
-
'Koe lost milde mastitis vaak zelf op'
15-07-2016 - Een milde mastitis wordt volgens Henk van Ruitenbeek, dierenarts bij De Oosthof Dierenartsen, regelmatig onnodig behandeld.
-
Vanaf 2017 antibioticabeleid per sector
09-07-2016 - Het antibioticabeleid wordt vanaf volgend jaar per sector bepaald. In 2017 worden de reductiedoelen voor 2020 vastgesteld.
-
Ei vaccineren biedt kuiken bescherming
22-06-2016 - Varianten van afweereiwitten uit het aangeboren immuunsysteem, kunnen een alternatief zijn voor antibiotica. In haar promotieonderzoek toont Tryntsje Cuperus voor het eerst aan dat dit...
-
Ei vaccineren biedt kuiken bescherming
22-06-2016 - Varianten van afweereiwitten uit het aangeboren immuunsysteem, kunnen een alternatief zijn voor antibiotica. In haar promotieonderzoek toont Tryntsje Cuperus voor het eerst aan dat dit...
-
TV: Wateroverlast kost boer miljoenen
08-06-2016 - In Nieuwe Oogst TV van woensdag 8 juni de volgende onderwerpen: LTO Nederland tevreden over daling antibioticagebruik, veel ondernemers getroffen door waterschade, Boerengilde lanceert...
-
TV: Wateroverlast kost boer miljoenen
08-06-2016 - LTO Nederland tevreden over daling antibioticagebruik, veel ondernemers getroffen door waterschade, Boerengilde lanceert Weide Weelde, Nederland verdient miljarden aan export agrosector en...
-
Proces-verbaal niet melden antibioticagebruik
20-05-2016 - Tegen twaalf pluimveehouders is proces-verbaal opgemaakt. Ze worden ervan verdacht vleeskuikens te hebben laten slachten zonder te melden dat de dieren met antibiotica waren behandeld.
-
Suske en Wiske en de strijd tegen antibiotica
14-04-2016 - Stripfiguren Suske en Wiske gaan de strijd tegen antibiotica aan. Dat doen ze niet alleen in het nieuwe album Tante Biotica, maar ook op een poster in de wachtkamer van dierenartsen.
-
Rem op antibioticagebruik Zuid-Europa
14-03-2016 - Het Europees Parlement heeft besloten dat Zuid-Europese landen niet langer royaal antibiotica kunnen inzetten in de landbouw.
-
Resistente coli daalt bij minder antibiotica
29-02-2016 - Een daling van antibioticagebruik leidt tot een daling van antibioticaresistente E.coli bacteriën in mestmonsters van kalveren, varkens en vleeskuikens. De mate van daling varieert sterk en...
-
Artsen bundelen krachten tegen ziekten
29-01-2016 - Experts op het gebied van de gezondheid van mens en dier van de Universiteit Utrecht, UMC Utrecht, Wageningen UR, Erasmus MC en het AMC gaan samen de strijd aan tegen antibioticaresistentie...
-
Veehouderij gebruikt minder 2e keus middelen
27-01-2016 - Zowel het totale gebruik van 2e keus diergeneesmiddelen als het aantal bedrijven dat deze middelen gebruikte is in 2014 gedaald. Dat schrijft staatssecretaris Van Dam in aanloop naar het...
-
LTO: laag antibioticagebruik belonen
23-01-2016 - LTO Nederland vindt dat veehouders die weinig diergeneesmiddelen gebruiken, moeten worden beloond. Dit kan onder andere door meer soepelheid ten aanzien van het gebruik en de opslag van...
-
Colistine resistentie ook in Nederland
17-12-2015 - Het Centraal Veterinair Instituut (CVI) heeft het recent in China beschreven overdraagbare colistine resistentiegen mcr-1 ook in Nederland aangetroffen. Colistine wordt bij de mens gebruikt...
-
Dikkers weigert excuses antibioticagebruik
02-12-2015 - Kamerlid Sjoera Dikkers (PvdA) neemt haar uitspraken over het antibioticagebruik in de veehouderij niet terug. En ze denkt er niet over om excuses te maken.
-
Illegale antibiotica in veren te zien
27-11-2015 - Met een nieuwe analysemethode kunnen onderzoekers aan de veren van pluimvee zien welke antibiotica deze dieren hebben gehad. Door de uitslag naast de boerderijadministratie te leggen, is te...
-
Ministerie VWS start antibioticacampagne
18-11-2015 - Het ministerie van VWS start in januari 2016 een driejarige campagne om aandacht te vragen voor een zorgvuldig gebruik van antibiotica.
-
Studie diergeneesmiddel en waterkwaliteit
09-11-2015 - De risico's van diergeneesmiddelen voor de waterkwaliteit zijn tot nu toe onderbelicht. Om dat te veranderen, brengt CLM de gevolgen van die emissiestroom in kaart.
-
Veehouder onderschat weerstandsproblemen
14-10-2015 - Veehouders onderschatten de weerstandsproblemen van koeien in de transitiefase. Ze zijn zich niet bewust van het effect van de transitie op de weerstand, onderschatten de duur en de...
-
Kamervragen over antibioticagebruik
05-10-2015 - De Europese richtlijnen rond antibioticagebruik zouden mogelijk minder ver gaan dan de Nederlandse regels. Dat is voor de VVD-Tweede Kamerleden Erik Ziengs en Helma Lodders reden om hier...
-
Eén rekenmethode voor antibiotica pluimvee
23-09-2015 - Momenteel zijn er in de pluimveesector twee rekenmethodes voor het antibioticumgebruik in gebruik. De insteek is nu dat de sector overgaat op één rekenmethode. Het doel is om per 1 januari...
-
Werkgroep Antibiotica verder onder POV-vlag
09-09-2015 - Werkgroep Antibiotica Varkens van Taskforce Antibioticaresistentie valt met ingang van 7 september onder de verantwoordelijkheid van de Producenten Organisatie Varkenshouderij (POV).
-
'Antibiotica melkvee niet altijd op temperatuur'
04-09-2015 - Ongeveer 30 procent van de melkveebedrijven bewaart antibiotica niet op de juiste temperatuur. Dat blijkt uit een onderzoek dat Paul Visscher uitvoerde voor zijn afstudeeropdracht bij de...
-
Zelfde bacterie bij bejaarde, kip en varken
15-07-2015 - Bewoners in een bejaardentehuis hebben dezelfde resitente bacteriën in hun darmkanaal dan kippen en varkens. Dat blijkt uit onderzoek van Karel Jacobs van de Universiteit van Gent.
-
Aanvullende maatregelen antibiotica
25-06-2015 - Minister Edith Schippers (VWS) heeft met verschillende partijen afspraken gemaakt over de strijd tegen antibioticaresistentie.
-
Enquêtes rond ervaringen UDD-regeling
09-06-2015 - Ruim een jaar geleden is de UDD-regeling van kracht geworden. Om inzicht te krijgen in de werking, wordt er een enquête gehouden onder veehouders.
-
Melkveesector blij met forse daling antibiotica
23-05-2015 - De melkveesector is content met een forse daling van het antibioticagebruik in deze tak. Uit gegevens van de Autoriteit Diergeneesmiddelen (SDa) blijkt dat het gemiddelde antibioticagebruik...
-
Daling gebruik antibiotica stagneert
21-05-2015 - De daling in het antibioticagebruik over alle diersectoren stagneert. Gerekend in dierdagdosering is het gebruik in 2014 gelijk aan het gebruik in 2013.
-
Schippers: geen extra zorg MRSA in Brabant
15-04-2015 - Er is op dit moment geen aanleiding voor extra zorgen over het voorkomen van infecties door MRSA of ESBL in Noord-Brabant. Dat laat minister Edith Schippers van Volksgezondheid weten.
-
Onderzoek problemen antibioticareductie
23-03-2015 - Komen dieren in problemen doordat veehouders en dierenartsen het antibioticagebruik zo laag mogelijk houden? Om hier antwoord op te krijgen, start staatssecretaris Sharon Dijksma (EZ) op...
-
Veearts wil antibiotica verder terugdringen
05-03-2015 - Dierenartsen gaan vanaf dit jaar met benchmarkwaarden werken, om het antibioticagebruik terug te dringen. Bij een dierdagdosering per jaar boven zes zijn directe maatregelen nodig om het...
-
SDa stelt benchmark varkens 2015 vast
24-02-2015 - Het expertpanel van de autoriteit Diergeneesmiddelen SDa heeft deze week nieuwe actiewaarden en signaleringswaarden vastgesteld voor de varkenshouderij. Daarbij wordt een stuk nauwkeuriger...
-
Dijksma: scherpere zelfcontrole veehouder
12-01-2015 - Om duidelijk te maken dat alle veehouders verplicht zijn tot zelfcontrole voor residuen van diergeneesmiddelen en verboden stoffen, scherpt staatssecretaris Sharon Dijksma (EZ) Regeling...
-
Controles veelgebruikers en illegale handel
10-12-2014 - De Nederlandse Voedsel- en Warenautoriteit (NVWA) zal bij haar controles op antibioticagebruik in de veehouderij in 2015 de nadruk leggen op veelgebruikers en niet-deelnemers in...
-
Gespeende biggen nieuwe benchmark
20-11-2014 - Vanaf 1 januari 2015 gelden drie benchmarkindicatoren voor varkens. Tot die datum zijn er twee: zeugen/biggen en vleesvarkens. Vanaf 2015 wordt de eerste groep uitgesplitst naar zeugen...
-
PIT over datamanagement en antibiotica
05-11-2014 - De komende maand zijn er twee sessies van de Pig Innovation Tour (PIT). Datamanagement staat op 20 november centraal en op 2 december antibiotica.
-
Veearts: meer antibioticagebruik
11-10-2014 - 70 procent van de dierenartsen stelt dat de huidige systematiek van formularia leidt tot een hoger gebruik van antibiotica. Dat blijkt uit een enquête van vakblad Veearts.
-
Mondiale strijd tegen antibioticaresistentie
27-09-2014 - Wereldwijd gaat op meerdere fronten tegelijk gestreden worden tegen antibioticaresistentie, aldus minister Edith Schippers van VWS.
-
Onderzoek VS naar antibiotica pluimvee
17-09-2014 - Amerikaanse senatoren willen een onderzoek naar antibioticagebruik in de pluimveehouderij in de Verenigde Staten (VS) na onthullingen van persbureau Reuters.
-
'Geen antibioticamelk naar kalveren'
03-09-2014 - Nog teveel melkveehouders voeren melk van met antibiotica behandelde koeien aan de kalveren. Daar moet echt een eind aan komen, vindt staatssecretaris Sharon Dijksma.
-
Grens aan antibioticareductie
13-08-2014 - In 2013 is het antibioticagebruik bij landbouwhuisdieren verder gedaald blijkt uit cijfers van de Autoriteit Diergeneesmiddelen (SDa). Aan het verder verder reduceren van het gebruik zit...
-
Overeenkomst over knelpunten antibiotica
02-08-2014 - De Koninklijke Nederlandse Maatschappij voor Diergeneeskunde (KNMvD) heeft met het ministerie van Economische Zaken overeenstemming bereikt over het oplossen van knelpunten bij het...
-
'Risico's furazolidon verwaarloosbaar'
30-07-2014 - Het is zonde dat kalveren moeten worden geruimd want het risico voor de volksgezondheid is verwaarloosbaar. Dat stelt Johanna Fink-Gremmels hoogleraar van de faculteit der Diergeneeskunde...
-
Bijeenkomst furazolidon van LTO en NVV
29-07-2014 - De LTO en NVV houden op vrijdag 1 augustus een bijeenkomst over furazolidon om in contact te komen met getroffen varkenshouders en elkaar te informeren.
-
Aantal gevallen vervuild veevoer onbekend
18-07-2014 - Het is nog onduidelijk hoeveel veehouderijbedrijven besmet veevoer hebben gehad. Dat zegt Frank Gort van Trust Feed, de organisatie die namens 86 diervoederbedrijven de veiligheid van aan...
-
Vervuild voer treft meerdere sectoren
18-07-2014 - De vervuiling van veehouderijbedrijven met het verboden middel Furazolidon is uitgebreid. Naast rundveebedrijven kunnen ook varkensbedrijven en paardenbedrijven zijn getroffen.
-
LTO: fraudeurs snappen het nog steeds niet
27-06-2014 - LTO Nederland neemt afstand van veehouders die willens en wetens verboden antibiotica gebruiken.
-
NVWA vindt fraude met antibiotica
26-06-2014 - Vijf kalverbedrijven en een rundveebedrijf zijn door de NVWA geblokkeerd. Ze worden verdacht van het gebruik van het verboden middel Furazolidon.
-
Samenwerking bij ontwikkeling antibiotica
26-06-2014 - Er moet worden gewerkt aan publiek-private samenwerking voor de ontwikkeling van nieuwe antibiotica. Dat is de uitkomst van een tweedaagse internationale conferentie over...
-
Van Hoof: beeld antibioticagebruik bijstellen
26-06-2014 - Deze week is in Den Haag een internationale conferentie over resistentieontwikkeling en het gebruik van antibiotica. De media besteden ruim aandacht aan de conferentie. Dat is volgens Toon...
-
Antibioticaresistentie niet verder toegenomen
26-06-2014 - De verkoop van antibiotica voor dieren is opnieuw gedaald. Dat duidt op minder antibioticagebruik en daardoor minder kans op resistentie. Dat blijkt uit de jaarlijkse Maran-rapportage.
-
Internationale conferentie antibiotica
21-06-2014 - Ministers uit 17 verschillende landen over de hele wereld zijn komende woensdag en donderdag in Den Haag aanwezig voor een conferentie rond de mondiale aanpak van antibioticaresistentie.
-
'Kritische middelen nog sporadisch gebruikt'
17-06-2014 - Volgens LTO Nederland zijn er grote stappen vooruit gezet bij de terugdringing van het antibioticagebruik. 'Goed nieuws is ook dat de voor de volksgezondheid kritische middelen nog maar...
-
SDa: antibioticagebruik varkens sterkste daler
17-06-2014 - De sterkste daling in het antibioticagebruik vond verleden jaar plaats in de varkens- en de vleespluimveehouderij met respectievelijk 30 en ruim 25 procent, meldt de Autoriteit...
-
Zes verdachten antibioticahandel vrijuit
13-06-2014 - Het Openbaar Ministerie (OM) mag zes mannen uit Groningen en Overijssel die worden verdacht van illegale handel met antibiotica in de pluimveesector, niet langer vervolgen.
-
Aanpak S. suis ondezocht
20-05-2014 - Een belangrijk deel van het antibioticumgebruik bij gespeende biggen is voor het bestrijden van Streptococcus suis (S. suis). In 2013 zijn op VIC Sterksel drie onderzoeken uitgevoerd met...
-
België: antibioticagebruik halveren voor 2020
12-05-2014 - Het totale antibioticumgebruik bij dieren halveren tegen 2020 en op termijn volledig afstoten van het onnodig gebruik van antibiotica in de diergeneeskunde. Die doelstelling streeft de...
-
Veehouder krampachtig bij ziek dier
06-05-2014 - Dierenartsen merken dat veehouders vaker twijfelen om een ziek dier te behandelen.
-
Antibiotica niet indelen naar bedrijfstype
15-04-2014 - Het is niet zinvol om het antibioticagebruik per bedrijfstype te registreren. Dat zegt staatssecretaris Sharon Dijksma (EZ) in een reactie op een verzoek van Wakker Dier.
-
Kennisuitwisseling met Indiase melkveesector
11-04-2014 - Een groep melkveehouders en dierenartsen vertrekt morgen naar India. Het betreft een kennisuitwisseling rond melkveehouderij gefinancierd door E-Motive en provincie Overijssel. Thema is...
-
'Resistentiedaling veehouderij verbluffend'
01-04-2014 - Onze runderen, varkens en kippen zijn in enkele jaren tijd beduidend minder resistent geworden voor antibiotica. 'En die trend zet zich door', zegt hoogleraar Dik Mevius.
-
EenVandaag in teken antibioticaresistentie
31-03-2014 - Onze koeien, varkens en kippen zijn minder resistent voor antibiotica, blijkt uit het MARAN-rapport. EenVandaag besteedde hier vandaag op de radio aandacht aan.
-
Benchmarken dierenartsen uniek in wereld
29-03-2014 - Nergens ter wereld wordt het voorschrijfgedrag van antibiotica door dierenartsen zo transparant gemaakt zoals in Nederland.
-
D66: dierenarts mag geen apotheker zijn
04-03-2014 - D66 vindt dat dierenartsen niet langer geld mogen verdienen aan medicijnen die ze zelf voorschrijven en verkopen.
-
Broodje aap: melk zit vol antibiotica
16-12-2013 - Het is een broodje aap dat melk vol zit met antibiotica. Dat meldt docent zuivelkunde Kasper Hettinga van Wageningen UR aan website The Milk Story.
-
Bottentest toont antibiotica in kuikens
18-11-2013 - Onderzoekers bij RIKILT Wageningen UR hebben een test ontwikkeld waarbij antibioticagebruik zichtbaar wordt in botten van slachtkuikens.
-
Daling antibiotica geiten nodig
12-11-2013 - Het antibioticagebruik in de beroepsmatige geitenhouderij moet omlaag. De sector moet daar werk van maken, vindt staatssecretaris Sharon Dijksma (EZ).
-
Richtlijnen gebruik antibiotica openbaar
04-11-2013 - De beroepsvereniging van dierenartsen heeft vandaag de eerste richtlijnen voor de Nederlandse dierenartsen openbaar gemaakt. Dat meldt de Koninklijke Nederlandse Maatschappij voor...
-
Dik Mevius stopt als voorzitter panel SDa
25-10-2013 - Dik Mevius stopt als voorzitter van het expertpanel van Stichting Diergeneesmiddelenautoriteit (SDa). Hij vertrekt per 1 januari 2014.
-
Antibiotica in VS steeds groter risico
01-10-2013 - Het gebruik van antibiotica als groeibevorderaar in veevoeding in de Verenigde Staten (VS) wordt een steeds groter risico voor de Amerikaanse volksgezondheid.
-
Nederland voorbeeld voor antibioticareductie
26-09-2013 - De Belgische veehouderij kan een voorbeeld nemen aan de Nederlandse voor wat betreft antibioticagebruik.
-
D66: zelfregulering landbouw volstaat niet
06-09-2013 - De vergaande zelfregulering van de agrarische sector is geen goede zaak. Dat stelt D66-Tweede Kamerlid Gerard Schouw.
-
'Zet dierdagdosering op Twitter'
12-08-2013 - Moeten boeren hun dierdagdosering op Twitter zetten? Arjan Swinkels van de biologische waterbuffelboerderij De Stoerderij, startte deze week op Twitter een discussie met deze suggestie.
-
Verbruik antibiotica melkvee 2,9 ddd/j
08-07-2013 - Het verbruik van antibiotica in de Nederlandse melkveehouderij lag in 2012 gemiddeld op 2,9 ddd/j. Dat blijkt uit de vandaag gepubliceerde overzichten van de SDa (autoriteit...
-
Boer mag zelf antibiotica toe blijven dienen
04-07-2013 - Veehouders houden de mogelijkheid zelf eerste keus antibiotica en een klein aantal tweede keus middelen toe te dienen bij hun dieren. Dat schrijven staatssecretaris Dijksma van EZ en...
-
Antibioticagebruik daalt verder
21-06-2013 - Het antibioticagebruik in de veehouderij is ten opzichte van 2007 met 56 procent gedaald. Ook de resistentieniveaus in dierlijke organismen namen daarmee af.
-
Belgen kunnen af met fors minder antibiotica
18-06-2013 - Op Belgische varkensbedrijven kan het gebruik van antibiotica met tientallen procenten omlaag zonder de productieresultaten negatief te beïnvloeden.
-
Dijksma: meer kennis ESBL hard nodig
28-05-2013 - De kennis over de manier waarop ESBL's zich verspreiden is beperkt. De overheid wil dat snel verbeteren. Dat schrijft staatssecretaris Sharon Dijksma (EZ) in een brief aan de Tweede Kamer.
-
Kamer wil onderzoek alternatieven antibiotica
17-04-2013 - Een meerderheid van de Tweede Kamer wil meer onderzoek naar alternatieven voor antibiotica.
-
Illegale handel in antibiotica: max. zes jaar cel
15-04-2013 - Overtreding van de voorschriften over handel in illegale antibiotica kan worden bestraft met een gevangenisstraf van maximaal zes jaar, een taakstraf of een geldboete van maximaal 78.000...
-
Kamer steunt reductie antibiotica
10-04-2013 - Een reductie van het antibioticagebruik van 70 procent in 2015 moet mogelijk zijn. Een grote meerderheid in de Tweede Kamer steunt deze doelstelling van staatssecretaris Sharon Dijksma...
-
Onduidelijkheid zelf toedienen antibiotica
10-04-2013 - Staatssecretaris Sharon Dijksma (EZ) wil vooralsnog het zelf toedienen van antibiotica door veehouders niet verruimen. Dat bleek gisteren tijdens een debat over antibiotica in de Tweede...
-
Dijksma handhaaft scherp antibioticabeleid
05-04-2013 - Het antibioticabeleid dat de sector en de regering in gang hebben gezet werpt duidelijk vruchten. De doelstellingen worden gehaald maar teugels worden flink strak gehouden.
-
Veehouder gebruikt nauwelijks 'zware' antibiotica
07-03-2013 - Antibiotica uit de groep van derde en vierde generatie cefalosporines zijn in 2011 op het overgrote deel van de Nederlandse dierhouderijen niet gebruikt. Op de overige bedrijven was het...
-
Denen gebruiken meer antibiotica bij varkens
05-03-2013 - Het antibioticagebruik bij varkens in Denemarken is het laatste jaar gestegen. De inzet van antibiotica steeg vorig jaar met 5,5 procent, meldt de Duitse website Agrar Heute.
-
Antibioticaregistratie varkens betrouwbaar
26-02-2013 - Het antibioticaregistratiesysteem dat door de varkenssector zelf is ontwikkeld en in een korte tijd is ingevoerd, blijkt een goede betrouwbaarheid te hebben.
-
'Duurzaamheid vraagt boerengevoel'
19-01-2013 - Ondernemers die duurzaam willen werken moeten meer afgaan op hun boerengevoel. Dat zegt Daan van Doorn, voorzitter van de Commissie Van Doorn.
-
Veelgebruik antibiotica aangescherpt
03-01-2013 - De grenzen voor het gebruik van antibiotica door veelgebruikers worden dit jaar aangescherpt. Dat meldt de Autoriteit Diergeneesmiddelen (SDa).
-
Wet Dieren per 1 januari van kracht
28-12-2012 - Op 1 januari 2013 gaat de Wet Dieren in. De wet stelt zelf een beperkt aantal regels en biedt daarnaast de mogelijkheid om allerlei zaken over en voor dieren te regelen.
-
'Richt aanpak antibiotica op mens en dier'
12-12-2012 - Het Europees parlement wil dat de Europese aanpak van antibioticagebruik zich richt op zowel menselijk als dierlijk gebruik. Ook moet ongepast gebruik van antibiotica stevig worden...
-
7.000 rundveehouders antibiotica niet op orde
28-11-2012 - Van de bijna 32.000 rundveehouders in Nederland, voldoen 7.000 rundveehouders nog niet aan de controleverplichting of de verplichting tot centrale registratie van de geleverde antibiotica.
-
Daling gebruik kritische antibiotica
27-11-2012 - De verkoop van 'kritische antibiotica', fluoroquinolonen en derde en vierde generatie cefalosporinen zijn gedaald. Dat meldt Co Verdaas, staatssecretaris van Economische Zaken.
-
'Antibioticagebruik kalkoenen aanscherpen'
27-11-2012 - De zorgvuldigheid van het antibioticagebruik in de vleeskalkoensector moet worden versterkt. Dat schrijven minister Edith Schippers (volksgezondheid) en staatssecretaris Co Verdaas...
-
EMA misleidt politici over antibiotica
20-11-2012 - Het Europese Medicijnen Agentschap (EMA) zet Nederlandse beleidsmakers en politici op het verkeerde been. Dat gebeurt door Nederland stelselmatig 'de slechtste' van de Europese Unie (EU) te...
-
NMa onderzoekt antibiotica
31-10-2012 - De Nederlandse Mededingingsautoriteit (NMa) bekijkt of de verplichte 1-op-1 relatie tussen veehouder en dierenarts in strijd is met de mededingingsregels.
-
'Grens reductie antibiotica onbekend'
30-10-2012 - Het is onzeker of het terugbrengen van het antibioticagebruik met 70% in 2015 ten opzichte van 2009 haalbaar is. 'We weten niet waar de grens ligt', stelt SDa-voorzitter Jos Werner.
-
Snijder voorzitter antibiotica-commissie
30-10-2012 - Oud-VVD-Tweede Kamerlid Janneke Snijder-Hazelhoff wordt voorzitter van de commissie die toezicht houdt op de werkwijze van Stichting Diergeneesmiddelenautoriteit (SDa).
-
'Geen kalvermelk met antibiotica'
30-10-2012 - Het voeren van melk met restanten van antibiotica is volgens Europese regelgeving niet toegestaan. EL&I-staatssecretaris Henk Bleker wil samen met de rundveesector maatregelen nemen om...
-
Antibiotica bij big beïnvloeden weerstand
29-10-2012 - Een (preventieve) antibioticumbehandeling bij pasgeboren biggen heeft invloed heeft op de weerstand van het varken. Dat blijkt uit een onderzoek van Wageningen UR en het CVI op het Varkens...
-
Goed gebruik antibiotica
01-09-2012 - Het Productschap Vee en Vlees (PVV) erkent Skal Biocontrole en IKB Nederland Runderen voorlopig als kwaliteitssysteem binnen de antibiotica regelgeving in de rundersector. Het schap heeft...
-
'Antibioticagebruik vergelijken kan niet'
27-08-2012 - Het vergelijken van het gebruik van antibiotica in de veehouderij tussen diverse landen, is nauwelijks mogelijk. Eenvoudige landenvergelijkingen gebaseerd op de totale verkoopcijfers van...
-
SDa: antibioticareductie moeilijk haalbaar
05-07-2012 - Het verminderen van antibiotica met 70% in 2015 voor alle veehouderijsectoren is wellicht een onhaalbare opgave. Dat heeft de SDa, de onafhankelijke autoriteit op het gebied van...
-
Bleker: 70% minder antibiotica in 2015
27-06-2012 - De veehouderij als geheel moet in 2015 een reductie in antibioticagebruik van 70% realiseren ten opzicht van 2009. Dat schrijft demissionair EL&I-staatssecretaris Henk Bleker in een...
-
Forse afname antibiotica varkens en pluimvee
15-06-2012 - De varkens- en pluimveesector hebben vorig jaar flink minder antibiotica gebruikt dan in 2009. Dat blijkt uit de nieuwste cijfers over het veterinair antibioticagebruik van het LEI.
-
Boete voor illegale handel antibiotica
13-06-2012 - Een handelsonderneming uit Genemuiden kreeg gisteren van de economische politierechter een boete van € 10.000, waarvan de helft voorwaardelijk. Dat gebeurde vanwege illegale handel in...
-
Antibioticagebruik 32% lager
06-06-2012 - Nederlandse veehouderijsectoren gebruikten in 2011 gemiddeld 32% minder antibiotica dan in 2009. De doelstelling van 20% reductie is daarmee ruimschoots gehaald.
-
Ormel: onkunde veearts ontoelaatbaar
05-06-2012 - Het is ontoelaatbaar als veeartsen te veel of ondeskundig antibiotica voorschrijven. Dat zegt CDA-Tweede Kamerlid en veearts Henk Jan Ormel.
-
LTO: antibioticabesluit veel te drastisch
05-06-2012 - Het antibioticabesluit van de regering is gebaseerd op incidenten en 2 onderzoeken uit het verleden. Het gaat aan de realiteit voorbij, laat LTO weten.
-
Ten Have: pijlen op groot- en veelgebruikers
01-06-2012 - Het ministerie van El&I moet de pijlen van haar antibioticabeleid richten op groot- en veelgebruikers. 'Alle voorgestelde maatregelen zijn voor de varkenssector al binnen IKB geregeld',...
-
Ook tekortkomingenantibiotica in kalversector
01-06-2012 - Ook in de blankvleeskalversector is het afleveren van een startpakket, antibiotica die worden gebruikt na aankomst van de kalveren op het kalverhouderijbedrijf, gemeengoed. Daarbij is in...
-
Netwerk van illegaal antibioticagebruik
01-06-2012 - De NVWA heeft een grootschalig netwerk van illegaal gebruik van antibiotica in de vleeskuikensector blootgelegd.
-
Alleen dierenarts mag antibiotica toedienen
01-06-2012 - Veehouders mogen niet langer antibiotica toedienen aan hun dieren. In de toekomst zal alleen de dierenarts daartoe bevoegd zijn. Dat laat staatssecretaris Henk Bleker weten.
-
Meer inzicht antibiotica geitenhouderij
08-05-2012 - Over het antibioticagebruik in de geitenhouderij is te weinig bekend. Dat moet de sector verbeteren. Dat antwoordt demissionair EL&I-staatssecretaris Henk Bleker op vragen van de Partij...
-
'Restrictie preventieve antibiotica'
28-03-2012 - Verschillende soorten antibiotica mogen niet meer preventief en groepsgewijs gebruikt worden. Dat schrijft de gezondheidsraad in haar jaarverslag dat deze week verscheen.
-
'Antibiotica camoufleert slecht management'
24-02-2012 - Veehouders moeten niet steeds naar medicijnen grijpen, maar zichzelf veranderen. Antibioticagebruik is een camouflagemiddel voor slecht management. Dat vindt mede-eigenaar Mark Schippers...
-
PPE: Consumentenbond ongenuanceerd over ESBL
31-01-2012 - De pluimveesector reageert verbolgen op het vandaag uitgebrachte Consumentenbondrapport over ESBL op kippenvlees in Nederlandse supermarkten.
-
ESBL op bijna alle kip in Nederlandse supers
31-01-2012 - Bijna alle kip in Nederlandse supermarkten is besmet met de ESBL-bacterie. Dat schrijft de Consumentenbond vandaag.
-
Antibioticagebruik België daalt langzaam
24-01-2012 - Het antibioticagebruik in de Belgische veehouderij is vorig jaar met 1,6% verminderd.
-
Wakker Dier daagt Bleker om ESBL's
10-01-2012 - Wakker Dier eist dat staatssecretaris Henk Bleker van EL&I de namen van supermarkten bekendmaakt waar door de NVWA resistente bacteriën op vlees zijn gevonden. De...
-
Vleeskuikensector haalt doelstelling antibiotica
20-12-2011 - De vleeskuikensector haalt de doelstelling voor 2011 om 20% minder antibiotica te gebruiken ten opzichte van 2009.
-
nVWA: investeer in drinkwaterinstallatie
30-11-2011 - Veehouders moeten investeren in deugdelijke drinkwaterinstallaties, vindt de nieuwe Voedsel en Waren Autoriteit (nVWA). Sinds kort kunnen veehouders geen veevoeder meer kopen waarin...
-
'Antibioticagebruik gaat goede kant op'
28-11-2011 - Het antibioticagebruik in de veehouderij is in 2011 flink lager dan in 2009. De doelstelling van 20% minder wordt ruimschoots gehaald. In 2013 moet het gebruik 50% lager zijn dan in 2009.
-
EC: minder antibiotica in veehouderij
17-11-2011 - De Europese Commissie wil het gebruik van antibiotica in de veehouderij aan banden leggen. Dat gebeurt om resistentie tegen te gaan, meldt NOS Teletekst.
-
Met succes verlagen antibiotica
14-10-2011 - De 3 winnaars van de Minder antibiotica: Yes we can!’ awards zijn bekend. Zij wonnen uit de groep van 19 varkensbedrijven. Alle inspirerende verhalen over vermindering in het...
-
MRSA verdwijnt snel bij kort kalfcontact
28-09-2011 - De LA-MRSA–bacterie kan gemakkelijk overgedragen worden aan mensen, maar slechts enkelen blijken de bacterie langdurig te dragen. Dat ontdekte onderzoeker Haitske Graveland van Universiteit...
-
Lui geworden in hygiëne
22-09-2011 - De Nederlandse veehouderij krijgt vaak de beschuldigende vinger in haar richting als er weer een ziekte opduikt. Te veel landbouwhuisdieren zou een onaanvaardbaar risico zijn. Ziekenhuizen...
Meest bekeken
Meest gelezen
Kennispartners
Vacatures
Redacteur Business & Markten
Nieuwe Oogst - Zwolle, Nederland
Agriwerker
Stichting Proefboerderijen Noordelijke Akkerbouw - Munnekezijl, Noordoost-Friesland
Agrarisch Onderzoeker/Projectleider
Stichting Proefboerderijen Noordelijke Akkerbouw - Munnekezijl En Nieuw Beerta
Agrarisch medewerker
KWS Benelux BV - Nagele (Noordoostpolder)
Manager Proefvelden
KWS Benelux BV - Nagele (Noordoostpolder)
Thema's
Weer
-
Vrijdag18° / 12°90 %
-
Zaterdag18° / 13°35 %
-
Zondag18° / 12°15 %